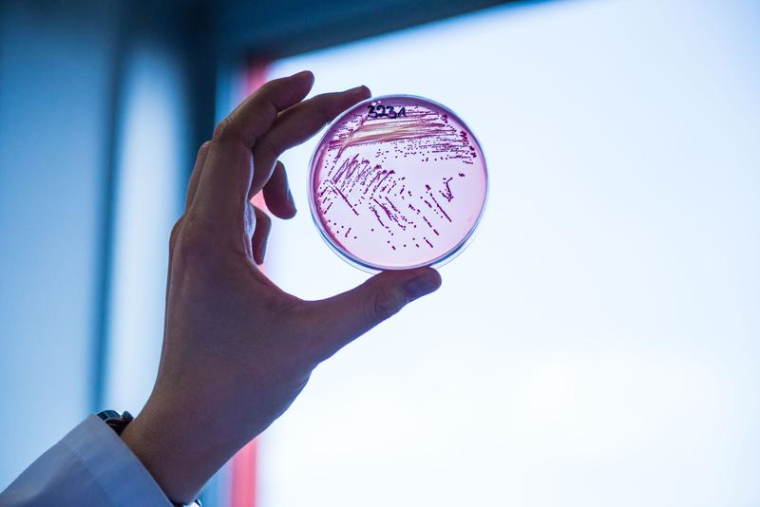
Selektivagarplatte, auf der ein multiresistenter Escherichia coli-Stamm...

Neuartiges Antibiotikum gegen Problemkeime in Sicht
Ein internationales Forscherteam mit Beteiligung der Universität Gießen entdeckt neuen Wirkstoff gegen gramnegative Bakterien – Darobactin attackiert die Erreger an einem bislang unbekannten Wirkort
Immer mehr bakterielle Erreger von Infektionskrankheiten entwickeln Resistenzen gegen die marktüblichen Antibiotika. Typische Krankenhauskeime wie Escherichia coli und Klebsiella pneumoniae haben Resistenzen gegen die meisten – und in einigen Fällen sogar alle – Antibiotika erlangt, die derzeit zur Verfügung stehen. Was diese Bakterien so schwer angreifbar macht, ist ihre zusätzliche äußere Membran. Sie schützt die Bakterien besonders gut, indem sie viele Substanzen nicht an ihren Wirkort gelangen lässt. Insbesondere zur Behandlung von Krankheiten, die durch diese sogenannten gramnegativen Bakterien verursacht werden, fehlen neue Wirkstoffe. Ein internationales Forscherteam mit Beteiligung von Wissenschaftlern der Justus-Liebig-Universität Gießen (JLU) hat nun ein neuartiges Peptid entdeckt, das gramnegative Bakterien an einem bislang unbekannten Wirkort angreift.
„Seit den 1960er-Jahren ist es nicht gelungen, eine neue Klasse an Antibiotika gegen gramnegative Bakterien zu entwickeln, aber dies könnte jetzt ein Kandidat dafür sein“, so Prof. Dr. Till Schäberle vom Institut für Insektenbiotechnologie der JLU und Projektleiter am Deutschen Zentrum für Infektionsforschung (DZIF), dessen Arbeitsgruppe an der Entdeckung beteiligt ist. Die Wissenschaftler nutzten ein Screening, einen klassischen Ansatz aus der Naturstoffforschung. Dabei testete das Team von Prof. Kim Lewis, Ph.D., Northeastern University in Boston, Massachusetts (USA), Extrakte bakterieller Symbionten von entomopathogenen Fadenwürmern auf eine Aktivität gegen E. coli. So gelang es den Forschern, ein Peptid zu isolieren, das sie Darobactin genannt haben.
Darobactin besteht aus sieben Aminosäuren und zeigt strukturelle Besonderheiten. So sind mehrere Aminosäuren über ungewöhnliche Ringschlüsse verknüpft. Die Substanz zeigt keine Zelltoxizität – eine Voraussetzung für den Einsatz als Antibiotikum. „Wir konnten bereits Einblicke gewinnen, wie die Bakterien dieses Molekül synthetisieren“, so Prof. Schäberle. „Nun arbeiten wir im Bereich Naturstoffforschung des Instituts für Insektenbiotechnologie der JLU daran, die Produktion dieser Substanz zu erhöhen und Analoga zu generieren.“
Die Wissenschaftler ermittelten auch den Wirkort von Darobactin. Sie stellten fest, dass Darobactin an das Protein BamA bindet, das in der äußeren Membran gramnegativer Bakterien lokalisiert ist. Dadurch wird der Aufbau einer funktionalen äußeren Membran gestört und die Bakterien sterben ab. „Besonders interessant ist, dass dieser bislang unbekannte Angriffspunkt außen liegt und Substanzen ihn einfach erreichen können“, erläutert Prof. Schäberle.
Darobactin zeigte eine hervorragende Wirkung bei Infektionen mit sowohl Wildtyp- als auch antibiotikaresistenten Pseudomonas aeruginosa-, Escherichia coli- und Klebsiella pneumoniae-Stämmen. Damit stellt Darobactin eine vielversprechende Leitstruktur zur Entwicklung eines neuen Antibiotikums dar. Wie dringlich dies ist, zeigt auch die Tatsache, dass die Weltgesundheitsorganisation (WHO) den Forschungs- und Entwicklungsbedarf gegen die resistenten Erreger mit höchster Priorität für die menschliche Gesundheit eingestuft hat.











